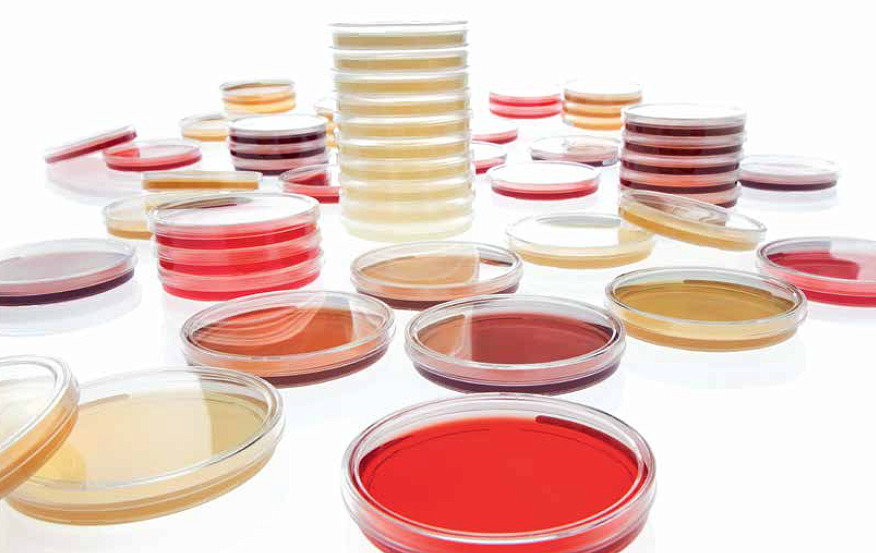
Для заказа доступны готовые среды для обнаружения микоплазм производства компании Merck Life Science (HEIPHA)

Для заказа доступны готовые среды для обнаружения микоплазм производства компании Merck Life Science (HEIPHA)
Теперь доступны для заказа следующие готовые среды для обнаружения микоплазм производства компании Merck Life Science (т.м. HEIPHA)
1 августа 2017
Теперь доступны для заказа следующие готовые среды для обнаружения микоплазм производства компании Merck Life Science (т.м. HEIPHA):
- 1463110001: Бульон Фрея (температура хранения 2-8)
- 1461800001: Бульон Фриса (температура хранения 2-8)
- 1460060020: Агар Фрея (температура хранения 4-12)
- 1460070020: Агар Фриса (температура хранения 4-12)
- 1464520001: Бульон Хайфлика (температура хранения 2-8)
- 1460290020: Агар Хайфлика, чашки (температура хранения 4-12)
Для получения более подробной информации обращайтесь к менеджерам отдела продаж, либо по телефону +7 (495) 134-5566.
Раздел закрыт в связи с обновлением содержания
Вопросы по содержанию раздела можно задать через форму обратной связи
Вопросы по содержанию раздела можно задать через форму обратной связи